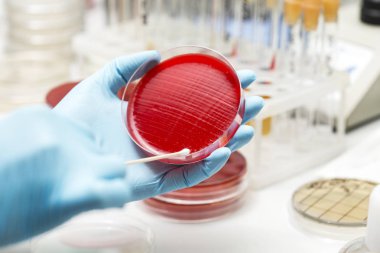
Laboratuvar teknisyeninin eli petri kabı yerleştiriyor.
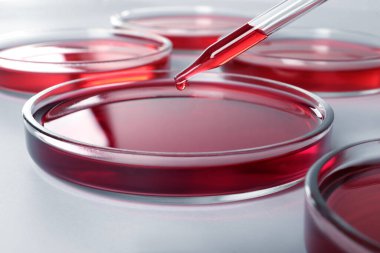
Beyaz arkaplanda Petri kabına kırmızı sıvı damlatılıyor, yakın plan
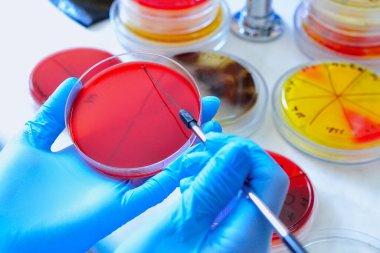
Petri kabı. Mikrobiyoloji laboratuvarı. Küf ve mantar kültürleri. Bakteriyel araştırma
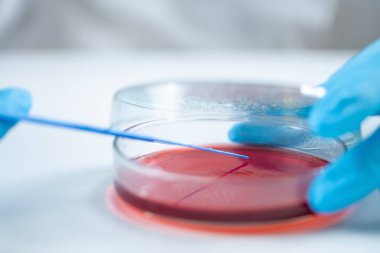
Mikrobiyolog, biyomedikal laboratuvarda araştırma yapmak için petri kabında kan tarımı aşıladı..

Mikrobiyoloji laboratuvarında biyolojik örneklerin analizi için petri kabı. İdrarın kültürü. Petri kalıpları ve tüpler idrar kültürü testi için.
Özel Boyut
(5184 x 3456, jpg)
Geniş Lisanslama
(5184 x 3456, jpg)
En Çok Aranan Kelimeler
Arkaplanİzole edilmişdonanımTutuluyorbüyümeSağlıkTabakİlaç.Sağlık hizmetleriTıbbiEl.biyolojikKlinikHücreTest etHastalıkkültürörnekbiyolojiKimyasalDeneyLaboratuvarBilimkanserortamvirüsBakteriaraştırmaanalizBilimselAnaliz etBiyoteknoloji.BakterilerMikroskopDöngüYerleştirmeMikrobiyolojipipetEnfeksiyonkolonileraşılamaPetripastörimmanuel kantPipettingaşıBenzer İçerikler